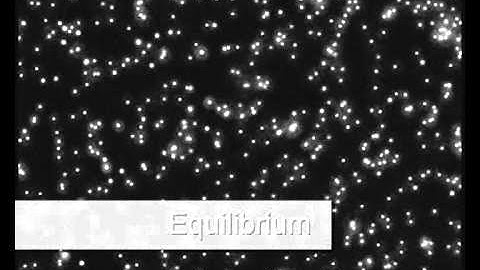
Stop flow in microfluidic device - Elveflow

⬇ DOWNLOAD NOW
Kalau muncul iklan pop-up, tutup lalu klik tombol kembali
Download lagu stop flow in microfluidic device SHORT secara gratis hanya untuk keperluan promosi. Dukung artis favorit kamu dengan membeli musik original di iTunes atau platform resmi lainnya.
Stop flow in microfluidic device - Elveflow
Stop flow in microfluidic device - Elveflow
 Microfluidic droplets stop flow
Microfluidic droplets stop flow
 Microfluidic stop flow and voltage control
Microfluidic stop flow and voltage control
 Flow Control in Microfluidic Devices
Flow Control in Microfluidic Devices
 QuickerSim CFD Toolbox - Laminar Flow in Microfluidic Device
QuickerSim CFD Toolbox - Laminar Flow in Microfluidic Device
 Microfluidic flow control
Microfluidic flow control
 Microfluidics device 2
Microfluidics device 2
 Microfluidic double emulsion stop flow
Microfluidic double emulsion stop flow